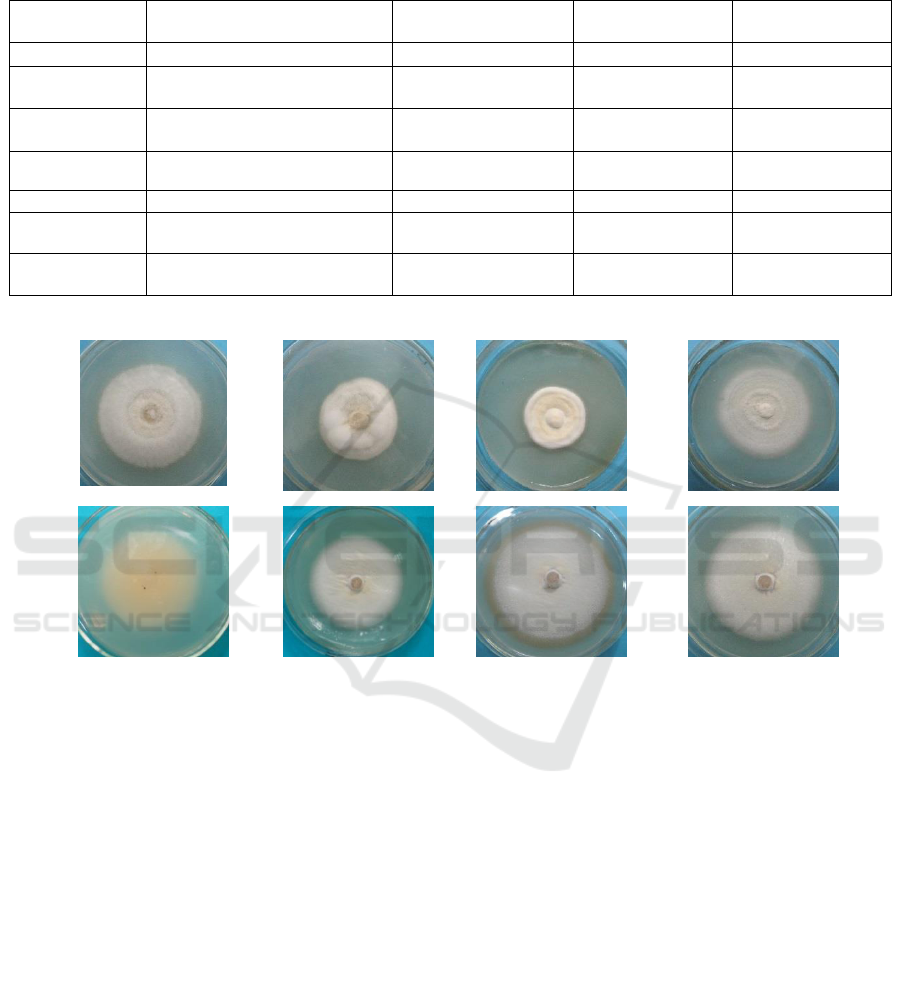

Mutation of Beauveria Bassiana Using Low-energy N
+
Implantation
and Selection of a High Virulence Strain
Xiaojun Deng
1
, Jian Tang
1
, Guoying Zhou
2*
and Jizhao Cao
1
1
Guangxi Zhuang Autonomous Region Fotestry Research Institute, Guangxi Key Laboratory of Superior Timber Trees
Resource Cultivation, Key Laboratory of Central South Fast-growing Timber Cultivation of Forestry Ministry of China,
Nanning 530002, Guangxi, China
2
Central South University of Forestry &Technology, Changsha 410004, Hunan, China
Keywords: N
+
implantation, Beauveria bassiana, Mutation breeding, Biston marginata.
Abstract: Low-energy ion implantation technology was used to generate mutants of the high virulence Beauveria
bassiana strain BbIII and bioassays were carried out on Biston marginata. The survival rate curve of B.
bassiana to doses of N
+
showed a “saddle shape.” The peak value 15 × 10
14
ions·cm
-2
was the optimal dose for
mutagenesis. The growth characteristics of B. bassiana, such as colony morphology, sporulation, and spore
germination rate, were affected by N
+
implantation. Three stains of B. bassiana were selected based on
sporulation, chitinase, and Pr1 enzyme activity as the screening indices. The activities of chitinase and Pr1
enzyme in Bb III 22 were 0.230 and 0.137 (OD value), and these were almost twice that of the original strain.
The Bb III 22 strain was the most virulent to B. marginata and the mortality was > 86.7% at a concentration of
10
7
spores·mL
-1
. The log LD
50
of the mutant strain spores against B. marginata was 5.1951 (4.5174~5.8416).
The results indicate that low-energy N
+
implantation and mutation can be effective for increasing the
virulence of Beauveria bassiana.
1 INTRODUCTION
Beauveria bassiana (Bals.) Vuillemin is an
entomopathogenic fungus, many strains of which
have been formulated for arthropod pest control
(Castrillo et al., 2003). Excessive use of chemical
pesticides has increased the “3R (Resistance,
Resurgengce, Residue)” problem. Alternative
biocontrol agents, such as B. bassiana, remain
effective for pest control and more attention should
be given to their production and application (Li et al.,
2006; Fernandes et al., 2008; Li et al., 2009).
Low-energy ion implantation is a mutation breeding
technique invented in China (Yuan and Yu, 2003).
Ion beams produce energy deposition, momentum
transfer, and strong ionization in the target
organisms. Indirect injury is produced by
highly-reactive radicals. Low-energy ion
implantation is an efficient, safe, and pollution-free
mutagenic method. It has the advantages of a broad
mutation spectrum, light ancillary damage, and
induction of stable mutations.
Low-energy ion implantation has been used in
rice, wheat, cotton, and tomatoes (Dai et al., 2007;
Xin et al., 2007; Yu et al., 2007). The mutagenic
effects of ion implantation Streptomyces are
recognized, and it is now widely used in microbial
selection (Li et al., 2011; Yuan et al., 2003; Song et
al., 2004; Zhu et al., 2006). The avila
neomycin-producing strain of Streptomyces was
mutagenized by low-energy N
+
implantation and the
resulting mutants had yields that were 41.4% to
47.2% greater than the parent strain (Zhu et al.,
2006). However, the application of N
+
implantation
in B. biassana has not been reported.
Since mutagenesis methods generate random
mutations, it is difficult to target mutations to produce
desired results. These methods require considerable
screening work and this reduces the efficiency of
mutation-based selection. Sporulation, Pr1 protease,
and chitinase activity appear to be associated with
microbial virulence (Peng et al., 2000; Feng, 1998).
Use of these indicators as secondary screening
methods for mutation breeding can improve
screening efficiency. We studied the mutagenic
effects of low-energy N
+
implantation on B. bassiana
to determine the optimal mutagen dose. Several
Deng, X., Tang, J., Zhou, G. and Cao, J.
Mutation of Beauveria Bassiana Using Low-energy N+ Implantation and Selection of a High Virulence Strain.
DOI: 10.5220/0008184800190024
In The Second International Conference on Materials Chemistry and Environmental Protection (MEEP 2018), pages 19-24
ISBN: 978-989-758-360-5
Copyright
c
2019 by SCITEPRESS – Science and Technology Publications, Lda. All rights reserved
19

mutagenized strains were then selected for their
higher virulence.
Camellia oleifera Abel (from Theaceae family)
originated from China. It occurs in 18 provinces or
municipalities in southern China, especially those
south of Hunan and Guangxi Provinces. Tea oil
(Camellia oleifera oil) is a high-quality edible oil
(Lee et al., 2007) containing oleic acid, unsaturated
fatty acids, and monounsaturated fatty acids. It is one
of the four primary edible tree oils (Zhang et al.,
2007). More than 100 insects and mites attack the
roots, stems, leaves, and buds of Camellia oleifera in
China. Of these, Biston marginata Shiraki
(Lepidoptera: Geometridae) is a key pest that causes
significant damage to tea oil plantations (Deng et al.,
2013). The larvae feed mainly on tender leaves,
which they skeletonize. Beauveria bassiana is an
important biological control agent used in Integrated
Pest Management systems because it is efficient, easy
to apply, economical, and effective against many
insect pests. We studied the the mutagenic effect of
low-energy nitrogen ion implantation on B. bassiana
and determined the best mutagenic dose. Our goal
was to select a B. bassiana strain with superior
virulence to pests of Camellia oleifera, specifically B.
marginata, and to provide guidance for the effective
use of this strain.
2 MATERIALS AND METHODS
2.1 Materials
B. bassiana Bb III was obtained from the Culture
Preservation Center (Central South University of
Forestry &Technology). SDY (Sabouraud Dextrose
Agar with Yeast Extract) medium consisted of 10
g·L
-1
peptone, 40 g·L
-1
glucose, and 10 g·L
-1
yeast
extract. Chantui induction medium had 2 g·L
-1
chantui powder (diameter<0.02), 0.2 g·L
-1
KH
2
PO
4
,
and 0.2 g·L
-1
MgSO
4
. Acetate buffer was made with
0.1 mol·L
-1
sodium acetate (pH 5.0). Boric acid KOH
buffer was composed of 0.8 mol·L
-1
boric acid,
adjusting the pH to 10.0 with KOH. DMAB solution,
1.0 g DMBA (P-dimethylaminobenzaldehyde), was
dissolved in 90 mL of glacial acetic acid and 10 mL
of hydrochloric acid. Suc-(Ala)
2
-Pro-Phe-pNA,
Tween-80 and Tris were purchased from
Sigma-Aldrich Co. LLC, and the others were AR
grade reagents made in China.
2.2 Methods
2.2.1 Preparation of Spore Suspension
The BbIII strain was added to a 9-cm Petri dish
containing about 10 mL SDY medium and incubated
at 25°C and relative humidity 69% for 14 d resulting
in a large number of spores. the dish was then washed
with 0.1% Tween-80 and the mycelium filtered by
sterile cotton. The spore concentration was adjusted
to approximately 10
6
spores·mL
-1
.
2.2.2 Low-energy N+ Implantation
The mutagenesis experiments were conducted using a
LZD-1000 ion implanter at the Forest Cultivation
Laboratory of Central South University of Forestry
&Technology in Changsha, China. We added a
uniform coating of 1 mL of the spore suspension to
sterile Petri dishes (9 cm) for ion implantation. The
target chamber vacuum was adjusted to 10
-3
Pa and
the ion implantation energy was 30 keV. We tested 9
doses: 3 × 10
14
, 6 × 10
14
, 90 × 10
13
, 12 × 10
14
, 15 ×
10
14
, 18 × 10
14
, 21 × 10
14
, 24 × 10
14
, and 27 × 10
14
(ions·cm
-2
). Non-irradiated Petri dishes in the target
room were the controls (CK). The velum was washed
with 1 mL sterile water after mutagenesis, coated
uniformity in Petri dishes of SDY medium, incubated
at 25°C, and counted after 5 d. All of the treatments
were repeated three times, and a graph was made with
the spore survival rate as the ordinate and implanting
dose as the abscissa.
2.2.3 Determination of Sporulation, Survival
Rate, and the Morphological Attributes
of Mutant Strains
The Bb III strain was mutagenized by N
+
implantation and then washed down with 1 mL sterile
water. The single-spore isolation method was
performed based on the method of Zhang (Zhang and
Zhang, 2009). We took the uniform 100 μL coating of
bacterial suspension exposed to radiation in the SDY
Petri dishes, incubated it at 25°C for 36 h, and picked
a single conidia under a dissecting microscope. We
continued to culture the selected stains and those with
high levels of sporulation were transferred to SDA
Petri dishes and saved. Details of colony morphology
were recorded.
Mutant strains were inoculated into 50-mL flasks
with SDY medium after activation by SDY tablet,
and incubated at 25°C, 160 r·min
-1
for 3 d. A 3-mL
sample of these cultures was inoculated into a 9-cm
MEEP 2018 - The Second International Conference on Materials Chemistry and Environmental Protection
20

SDY Petri dish and incubated at 25°C for 15 d. Then,
colony three holes (0.9-cm diam) were punched in the
colony and placed in 0.1% Tween-80 and faltered
with a high-speed disperser. Determination of
sporulation was made with a hemocytometer
Determination of spore survival rate was performed
using the method of Hong (Hong et al., 2001).
2.2.4 Enzyme Induction and Activity Assay
A loopful of slant culture was inoculated into a
50-mL flask with 15 mL SDY medium and incubated
at 25°C, 160 r·min
-1
for 3 d. A 0.2-mL portion of the
above seed cultures was inoculated into a 50-mL
flask with 15 mL Chantui induction medium and
cultured at 25°C, 160 r·min
-1
for 96 h. The
supernatant was centrifuged 14 000 r·min
-1
for 5 min
for three times and determined the activity of Pr1
protease.
Determination the activity of Pr1 protease was
performed using the method of St. Leger (St Leger et
al., 1987). A 30-μL of 0.04 mol·L
-1
Tris-HCl buffer
was added to 10 μL of the above supernatant and 10
μL of 1 mg·mL
-1
Suc-(Ala)
2
-Pro-Phe-pNA. The
response at 28°C for 10 min and the activity of Pr1
enzyme were measured as the optical density at 405
nm using a UV spectrophotometer (UNICO
Instruments Co., Ltd, China).
Preparation of colloidal chitin was performed
using the method of Hsu (Hsu and Lookwood, 1975).
Determination of chitinase enzyme activity was
performed using the method of Mauch (Mauch et al.,
1984), with slight modifications. A 100-μL sample of
the above supernatant cultures was combined with
100 μL colloidal chitin and 350 μL acetate buffer,
placed in a 28°C water bath for 2 h, and then
centrifuged for 5 min at 1,000 r·min
-1
. A 300-μL
portion of the above supernatant was combined with
100 μL boric acid KOH buffer, and then mixed with
2.5 mL DMAB after 3 min of boiling water, followed
by exposure to a 40°C water bath for 20 min. The
activity of the chitinase enzyme was measured as the
optical density at 540 nm using a UV
spectrophotometer.
2.2.5 Toxicity Test of the Mutants against B.
Marginata
We adjusted the spore concentration to 10
6
, 10
7
, and
10
8
spores·mL
1
with 0.1% Tween 80. The larvae that
had been treated with the mutant strains at different
doses were placed into glass vials (61 mm diameter ×
87 mm height) with 30 larvae per box provisioned
with Camellia leaves under laboratory conditions of
25°C and relative humidity 69% and a 12: 12 (L:D)
photoperiod.
All of the bioassays were replicated three times
with different mutant strain concentrations. Each
replication of each concentration included 1 vial with
30 larvae. Mortality was determined after every 24 h,
and larvae were considered dead if there was no
movement when they were prodded.
2.3 Statistical Analysis
Data were analyzed using DPS (Data Processing
System) version 9.05, and expressed as mean values
± SD. Student’s t test was used for testing the
significance of differences between treatments.
3 RESULTS
3.1 Low-energy N
+
Implantation Dose
Selection
We implanted different doses of N
+
with 30 keV of
energy, and the survival rate curve of Bb III is shown
in Figure 1.
As the N
+
implantation dose increased the
biomass declined. The survival rate was lowest at a
dose of 9 × 10
14
ions·cm
-2
. With an increasing
implantation dose, the survival rate increased slightly
at 15 × 10
14
ions·cm
-2
and then declined. The survival
rate curve of B. bassiana had a typical “saddle shape
(Yuan and Yu, 2003)” (Figure 1). Since the strain had
a relatively higher rate of good mutations when the
implantation dose was 15 × 10
14
ions·cm
-2
, this dose
was selected as optimum for mutagenesis, and its
survival rate was 26%.
0
20
40
60
80
100
0 5 10 15 20 25 30
Survi val rate /%
N
+
impl antation dose /10
14
ions·cm
-2
Figure 1: Viability of B. bassiana conidia at different
dosages of irradiation with 30 keV N
+
.
3.2 Sporulation and the Morphological
Observation of Mutant Strains
BbIII was subjected to ion implantation and six
mutants were selected on the basis of mycelial
growth rate and growth vigor (Table 1). The results
showed that the colony morphology of B. bassiana
was affected by N
+
implantation (Figure 2), and the
sporulation of the six mutants was improved. The
sporulation of Bb III 28 was 9.235 ± 0.023 (× 10
8
Mutation of Beauveria Bassiana Using Low-energy N+ Implantation and Selection of a High Virulence Strain
21
spores·cm
-2
), but its germination rate was slightly lower than the original strain.
Table 1: Morphology and growth characteristics of different B. bassiana strains.
Isolate
Colony morphology
Days for sporulation
(d)
Conidia amount
(108 spores·cm-2)
Germination rate
(%)
Bb III 05
White, flocculent
9
8.333±0.212b
91.23±0.21b
Bb III 13
Light yellow, powdery and
convex
7
7.034±0.089c
68.23±0.09f
Bb III 22
White, flocculent concentric
circles
7
7.340±0.112c
88.34±0.57d
Bb III 28
White, smooth concentric circles
7
9.235±0.023a
89.32±0.11c
Bb III 47
Hoar, flocculent
8
8.022±0.162b
92.63±0.30a
Bb III 83
White, flocculent and thick
7
7.218±0.067c
73.68±0.13e
Bb III
(Control check)
White, flocculent
8
6.315±0.012d
92.59±0.31a
Note: Data in the table followed with different letters are significantly different at P=0.01.
1
2
3
4
5
6
7
8
1. Bb III 22; 2. Bb III 05; 3. Bb III 13; 4. Bb III 28; 5. Bb III 22; 6. Bb III 47; 7. Bb III 83; 8. Bb III (Control check).
Figure 2: Variation in the morphology of B. bassiana strains.
3.3 Enzyme Induction and Activity
Assay
The activity levels of Pr1 enzyme were significantly
higher (p=0.01) in Bb III 05, Bb III 13, and Bb III 22
compared with the parent strain, and the activity
levels of chitinase enzyme were significantly higher
(p=0.01) in Bb III 05, Bb III 22, and Bb III 28
compared to the parent strain (Table 2). Total enzyme
activity levels in Bb III 22 were significantly higher
than in all seven strains, and almost two times that of
the parent strain.
3.4 Median Lethal Concentration
(LD50) Determined by Bioassay
Contact toxicity of the 3 mutants to larvae using a
glass-vial bioassay was determined. Mortality in all
of the control groups was consistently less than 5%.
The Bb III 22 strain was the most virulent to B.
Marginata, with 86.7% mortality at a concentration
of 10
7
spores·mL
-1
. DPS was used to analyze the
virulence regression equation and chi-square test
(Table 3). Equation Chi-square values of mutants
were 0.6003, 0.8132, and 0.2981. The P values were
0.7407, 0.6659, and 0.8615 (>0.05), which shows
that the virulence of the regression equation is
MEEP 2018 - The Second International Conference on Materials Chemistry and Environmental Protection
22

suitable. Bb III 22 had the highest toxicity, and its logarithmic LD
50
value was 5.1951 (4.5174~5.8416).
Table 2: Activity of chitinase and Pr1 enzyme in different B. bassiana strains.
Isolate
Pr1 enzyme activity (OD
405nm
)
Chitinase activity (OD
540nm
)
Bb III 05
0.140±0.015b
0.098±0.017b
Bb III 13
0.158±0.024b
0.053±0.009c
Bb III 22
0.230±0.017a
0.137±0.021a
Bb III 28
0.105±0.031bc
0.143±0.011a
Bb III 47
0.028±0.007d
0.085±0.013bc
Bb III 83
0.096±0.011bc
0.059±0.010c
Bb III
(Control check)
0.078±0.013c
0.073±0.005bc
Note: Data in the table followed with different letters are significantly different at P=0.01.
Table 3: Equations of LC-P and Chi-test of B. bassiana mutants against Biston marginata.
Mutants
Regression equation
Correlation
coefficient
Ψ
P
LD
50
95% Confidence
limits
Bb III 05
Y=2.3382+0.4262x
0.9941
0.6003
0.7407
6.2458
5.5960-7.5760
Bb III 22
Y=2.2649+0.5265x
0.9643
0.8132
0.6659
5.1951
4.5174-5.8416
Bb III 28
Y=2.1543+0.4313x
0.9959
0.2981
0.8615
6.5979
5.8890-8.5143
4 DISCUSSION
Strains of BbIII were mutagenized by low-energy N
+
implantation. We implanted different doses of N
+
and
the resulting survival rate curve of B. bassiana
showed the typical “saddle shape.” With 12 × 10
14
, 15
× 10
14
, and 18 × 10
14
ions·cm
-2
dose treatments, the
mortality rate ranged between 70% and 80%. Since
the mutagenesis microbial death rate ranged from
70% to 75%, the positive mutation rate tended to be
higher. The positive mutation rate was very low and
the suitable mutagenic dose was 15 × 10
14
ions·cm
-2
.
Among the different mutant strains, colony
morphology, sporulation time, sporulation number,
and spore germination rate were significantly
different. This indicated that low-energy ion
implantation effected the physiology and
biochemistry of B. bassiana.
The survival curve of the ion implantation
treatments was saddle-shaped. With traditional
physical and chemical mutagenesis methods, the
survival curve is typically an index type or shoulder
type (Song et al., 1999;Yuan and Yu, 2003; Yuan et
al., 2003). Different combinations of ion number,
energy, and dose could provide a large number of
mutagenic conditions. The combined effects of the
ion implantation treatment and their strong influence
on cells has an advantage that traditional mutagenesis
techniques cannot match.
B. bassiana is an important insect pathogenic
fungus, and it has been widely used for the biological
control of pests. We developed three strains of B.
bassiana with high sporulation, high Pr1, and high
chitinase activity using N
+
implantation mutation
selection. These strains had high toxicity to B.
marginata, an economically important pest of
Camellia.
ACKNOWLEDGEMENTS
We thank the Key R&D Projects in the 13th
Five-Year Plan (2018YFD0600202) and the Project
on Special Funds for Innovation-driven Development
in Guangxi (AA17204087-11). We also thank the
Guangxi Science and Technology Base and Talent
Project (Gui ke AD17129051) for providing financial
support. We thank LetPub (www.letpub.com) for its
linguistic assistance during the preparation of this
manuscript.
REFERENCES
Castrillo, L. A., Vandenberg, J. D., Wraight, S. P., 2003.
Strain-specific detection of introduced Beauveria
bassiana in agricultural fields by use of
sequence-characterized amplified region markers[J].
Journal of Invertebrate Pathology, 82(2): 77-80.
Dai, X. M., Huang, Q. C., Hu, X. M., et al., 2007.
Development and character observation of
autotetraploid polyembryonic mutant rice induced by
ion beam implantation. Journal of nuclear agricultural
sciences, 21(1): 1-4.
Mutation of Beauveria Bassiana Using Low-energy N+ Implantation and Selection of a High Virulence Strain
23

Deng, X. J., Tang, J., Qin, Q. Y., et al., 2013. Primary
investigation of diseases and pests on oil camellia
(Camellia oleifera Abel) in Guangxi Province of China
and suggestions for prevention and control.[J]. Plant
Diseases & Pests, (6):35-38.
Feng, M. G., 1998. Reliability of extracellular protease and
lipase activities of Beauveria bassiana isolates used as
their virulence indices. Acta Microbiologica Sinica,
38(6): 461-467.
Fernandes, é., Bittencourt, V. 2008. Entomopathogenic
fungi against South American tick species[J].
Experimental and Applied Acarology, 46(1): 71-93.
Hong, T. D., Gunn, J., Ellis, R. H., et al., 2001. The effect of
storage environment on the longevity of conidia of
Beauveria bassiana. Mycological Research, 105(5):
597-602.
Hsu, S. C., Lookwood, J. L., 1975. Powdered chitin agar as
a selective medium to enumeration of actinomecetes in
water and soil. Applied Microbiology and
Biotechnology, 29(3): 422-426.
Lee, C. P., Shih, P. H., Hsu, C. L., et al., 2007.
Hepatoprotection of tea seed oil (Camellia oleifera
Abel.) against CCl4-induced oxidative damage in rats.
Food Chem Toxicol, 45: 888–895.
Li, M. Y., Lin, H. F., Liu, S., et al., 2009. Study on medium
and cultivation conditions to increase spore yied of
Beauveria brongniartii. Biotechnology Bulletin, S1:
380-383.
Li, M., Wang, S. B., Pan, M. Z., et al., 2006. Genetic
dicversity of Beauveria bassiana (Bals.) Vuill. in forest
ecosystem assessed by inter-simple sequence repeat
(ISSR) markers. HEREDITAS (Beijing ), 28(8):
977-983.
Li, S. C., Liu, H. X., Zhu, C. Y., et al., 2011. Screening of
lipid-producing strain Rhodotorula glutinis by
low-energy ion implantation. Journal of the Chinese
Cereals and Oils Association, 26(8): 31-35.
Mauch, F., Hadwiger, L. A., Boller, T., 1984. Ethylene:
symptom, not signal for the induction of chitinase and
β-1, 3-glucanase in pea pods by pathogens and elicitors.
Plant Physiology, 76(3): 607-611.
Peng, G. X., Zhang, Y. J., Yang, X. Y., et al., 2000.
Relationship of the production of subtilisin-like
protease and total extracellular protease by Beauveria
bassiana with its virulence to Bombyx mori. Chinese
Journal of Biological Control, 16(2): 61-64.
Song, A. D., Chen, H. G., Jia, C. Y., et al., 2004. Effect of
ion implantation on apple wine yeast. Acta agriculturae
Nucleatae sinica, 18(3): 190-192.
Song, D. J., Yao, J. M., Wu, L. F., et al., 1999. The etching
of cells and damage and repair of DNA in deinococcus
radiodurans by N+ implantation. Hereditas (Beijing),
21(4): 37-40.
St Leger, R. J., Charley, A. K., Cooper, R. M., 1987.
Characterization of cuticle-degrading protease
produced the entomopathogen Metarhizium anisopliae.
Archives of Biochemistry and Biophysics, 253(1):
221-232.
Xin, Q. G., Liu, L. X., Yu, Y. J., et al., 2007. Ion beam
implantation technique and its application in wheat
breeding. Journal of triticeae crops, 27(2): 354-357.
Yu, Y. J., Wu, L. J., Wu, Y. J., et al., 2007. The methods for
examining the vitality of cotton pollen implanted by
nitrogen ion. Cotton science, 19(2): 102-105.
Yuan, C. L., Yao, J. M., Wang, J., et al., 2003. Breeding of
arachidonic acid-producing strain by low-energy ion
implantation. J. Radiat. Res. Radiat. Process, 21(4):
237-242.
Yuan, C. L., Yu, Z. L., 2003. The grand progress of
low-energy ion beam in life sciences. China
biotechnology, 23(4): 57-61.
Zhang, D. Q., Tan, X. F., Peng, W. X., et al., 2007.
Improved application of Camellia oleifera on biomass
energy by enlarging its production. Acta Sci Nat Univ
Sunsyatseni, 46(Suppl): 109–110.
Zhang, H. W., Zhang, G. Z., 2009. A simple and feasible
method for single-spore isolation from Cryphonectria
parasitica. Plant Protection, 35(3): 94-95.
Zhu, C. H., He, Y. N., Lu, F. P., et al., 2006. Study on
mutagenic effects of avilamycin-producing strain
induced by N+ ion implantation. Nuclear techniques,
29(8): 609-613.
MEEP 2018 - The Second International Conference on Materials Chemistry and Environmental Protection
24
